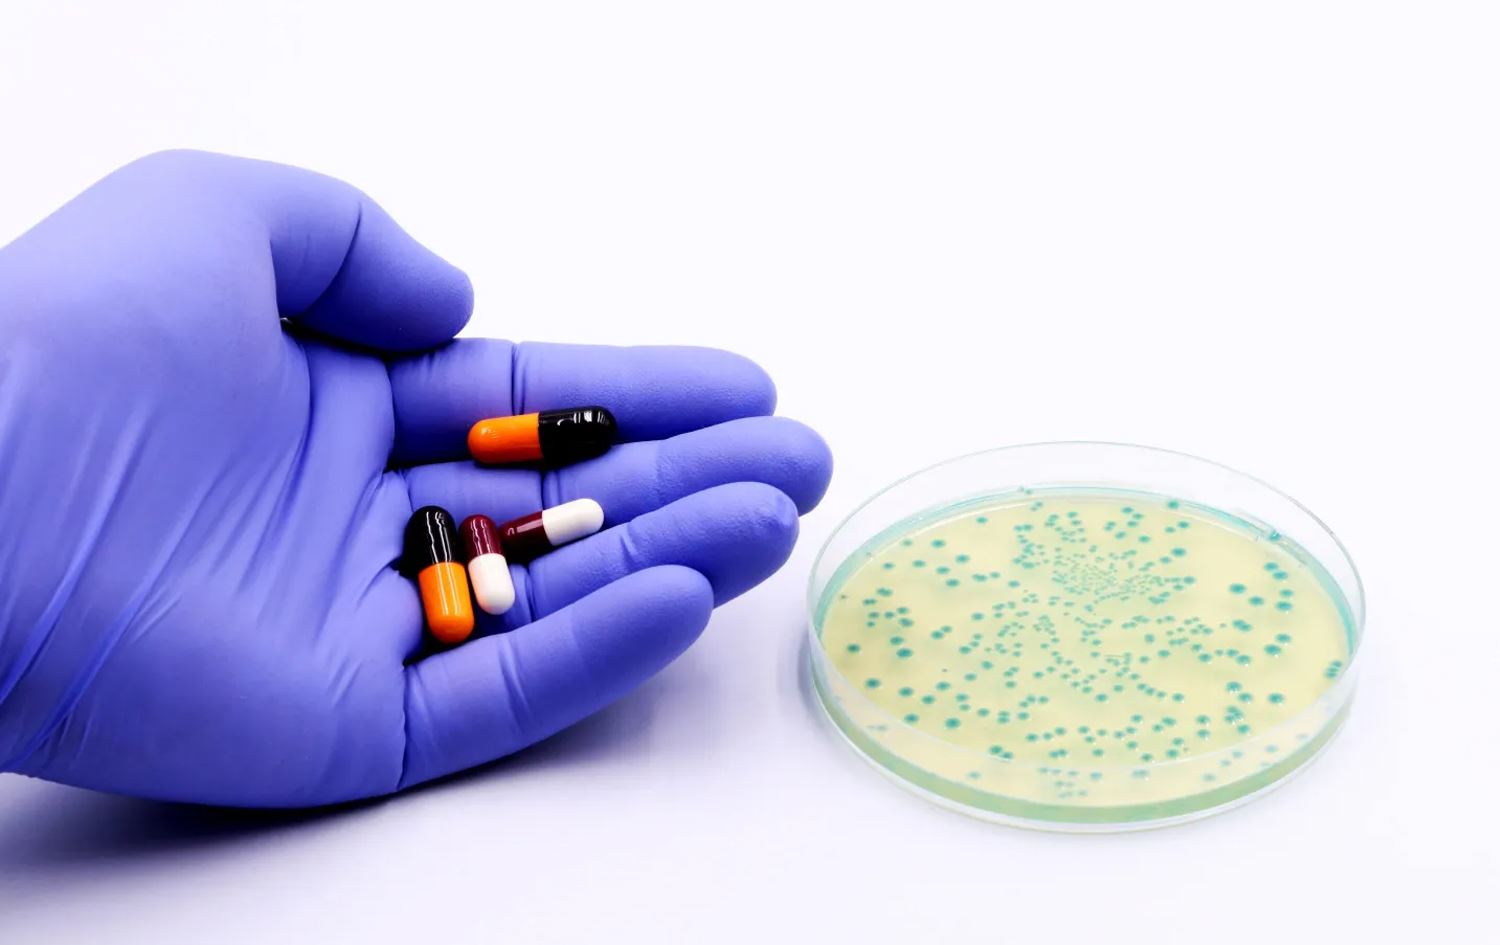

رووداو - تەندروستی
توێژینەوەیەکی جیهانیی ناوەندێکی بەریتانی ئاشکرای دەکات، مەترسیی بەهێزبوونی بەکتریاکان دەبێتە هەڕەشەیەکی جیدی بۆ سەر دانیشتووانی جیهان و هەموو تەمەنێکیش دەگرێتەوە.
ناوەندی پزیشکیی ژینگەیی و تەندروستیی گشتی لە ئینگلاند رایدەگەیێنێت، لە ماوەی 25 ساڵی داهاتوودا کێشەی بەهێزبوونی بەکتریاکان و نەمانی کاریگەریی دژەبەکتریاکان دەبێتەهۆی گیانلەدەستدانی زیاتر لە 39 ملیۆن کەس بە شێوەی راستەوخۆ و گیانلەدەستدانی 169 ملیۆن کەس بە شێوەی ناڕاستەوخۆ.
نوێترین توێژینەوەی ناوەندەکە دەریدەخات، ئەمساڵ بەراورد بە ساڵی رابردوو مردن بە بەهێزبوونی بەکتریاکان 75٪ زیادبووە.
هاوکات توێژەران هۆشداری دەدەنە وڵاتانی تازەپێگەیشتوو و کەمداهات بەتایبەت وڵاتانی ئەفریقا و باشووری ئاسیا، چونکە بەهۆی کەمیی هۆشیاریی تەندروستییەوە زیاتر تووشی ئەو کێشەیە دەبن.
دام سالی، نوێنەری نەتەوەیەکگرتووەکان بۆ پرسی بەهێزبوونی بەکتریاکان دەڵێت: کێشەکە گەورەترین مەترسیی لەسەر بەساڵاچووان دروستدەکات، چونکە بەرگرییان لاوازترە بەراورد بە کەسانی دیکە.
بەشێک لە ئامارە جیهانییەکان
- لە نێوان ساڵانی 1990 بۆ 2021 بەهێزبوونی بەکتریاکان و نەمانی کاریگەریی دەرمانەکانی دژەبەکتریاکان تاوەکو 2050 لە 204 وڵات دا بڵاودەبێتەوە.
- لە نێوان ساڵانی 1990 بۆ 2021 ساڵانە زیاتر لە ملیۆنێک کەس بەهۆی بەهێزبوونی بەکتریاکان و نەمانی کاریگەریی دەرمانەکانی دژەبەکتریاکان گیانیان لەدەستداوە، 80٪ـیان کەسانی بەساڵاچوو بوون.
- ژمارەی گیانلەدەستدان بەهۆی بەهێزبوونی بەکتریاکان تاوەکو ساڵی 2050، نزیکەی 70٪ زیاددەکات.

کۆمێنتەکان
وەک میوان کۆمێنتێك بنووسە یان وەرە ژوورەوە و ههموو خزمەتگوزارییەکان بهكاربێنه
کۆمێنتێک دابنێ